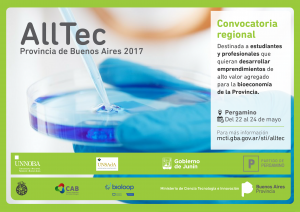
FLYER AllTec (2)

22 marzo, 2026
 PERGAMINO-“¿Atropellar a la prima se puede?” — “Si es peronista, sí”: la polémica respuesta del concejal Donato Cignoli
PERGAMINO-“¿Atropellar a la prima se puede?” — “Si es peronista, sí”: la polémica respuesta del concejal Donato Cignoli
 MISTERIO EN EL CIELO: CRECEN LOS REPORTES DE LUCES EXTRAÑAS EN LA ZONA SUR DE PERGAMINO
MISTERIO EN EL CIELO: CRECEN LOS REPORTES DE LUCES EXTRAÑAS EN LA ZONA SUR DE PERGAMINO
 VIOLENCIA EN EL AULA: UN ALUMNO ATACÓ A LA DIRECTORA Y PROVOCÓ DESTROZOS EN UNA ESCUELA
VIOLENCIA EN EL AULA: UN ALUMNO ATACÓ A LA DIRECTORA Y PROVOCÓ DESTROZOS EN UNA ESCUELA
 “LA MUNICIPALIDAD EN TU BARRIO” LLEGA A JORGE NEWBERY
“LA MUNICIPALIDAD EN TU BARRIO” LLEGA A JORGE NEWBERY
 PERGAMINO-ABSUELVEN A UN PADRE Y A SUS PADRES EN UNA CAUSA POR ABUSO INFANTIL
PERGAMINO-ABSUELVEN A UN PADRE Y A SUS PADRES EN UNA CAUSA POR ABUSO INFANTIL